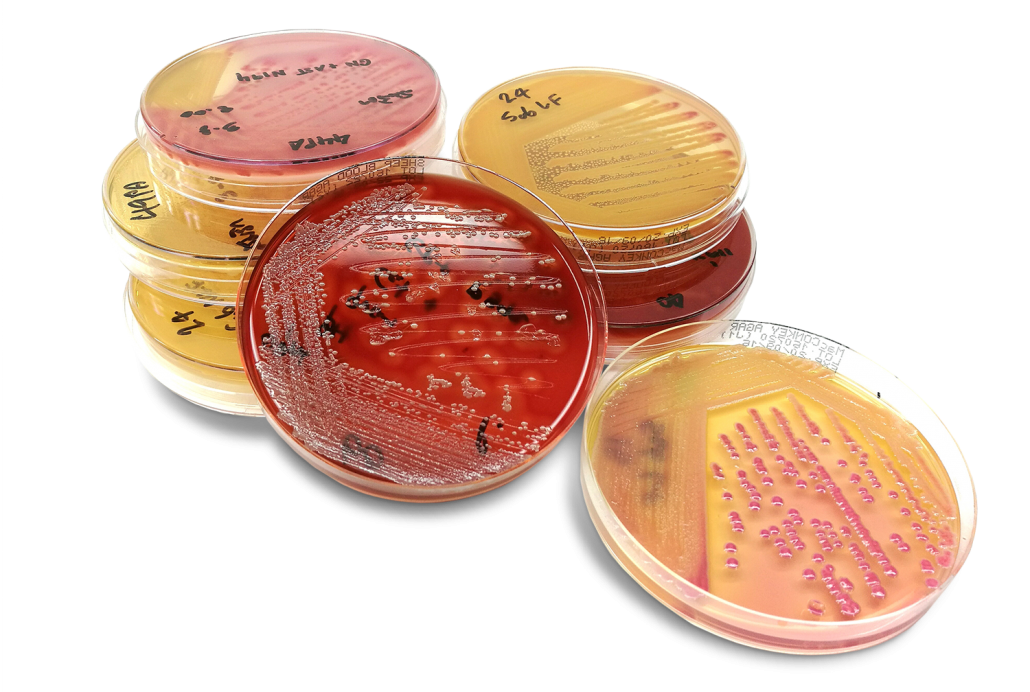
Produktproben im Fleisch-Technologiezentrum Hollabrunn FTZ

Fleisch-Technologiezentrum Hollabrunn (FTZ)
Lebensmittellabor, Schulung und Beratung
Das Fleisch-Technologiezentrum Hollabrunn (FTZ) ist Ihr Labor für Lebensmittelanalytik und Kompetenzzentrum für Schulungen und Beratungen rund um Lebensmittelsicherheit und Lebensmittelqualität, Lebensmittelhygiene inkl. Hygienekontrollen, HACCP und IFS sowie Produktentwicklung.
Kompetenzzentrum für Lebensmittelanalytik, Lebensmittelhygiene & Beratung
Wir unterstützen Sie im Rahmen der betrieblichen Eigenkontrolle im Sinne des § 21 LMSVG:
- Lebensmitteluntersuchungen gemäß EU-VO 2073/2005
- Haltbarkeitsermittlung
- Mikrobiologische und chemische Analysen, Untersuchungen hinsichtlich Verkehrsfähigkeit und Produktspezifikationen
- Fokussierung auf Fleisch und Fleischwaren
- Beratung und Hilfestellung rund um Lebensmittelsicherheit, Qualität und Zusammensetzung von Produkten
- Personalschulungen zu den Themen Hygiene, HACCP, IFS, Sensorik
- ausgelagerte Produktentwicklung für Unternehmen: nach Bedarf Vernetzung mit der Privaten HTL für Lebensmitteltechnologie und Einrichtungen der Fachschulen in Hollabrunn sowie Kooperationen mit externen Fachleuten
- Nutzung geförderter Beratungsleistungen für Gewerbebetriebe in Niederösterreich seitens des Lebensmittel-Clusters NÖ
Über uns
Ihr Lebensmittellabor in Niederösterreich
Wir prüfen und untersuchen Ihre Lebensmittelproben, beraten Sie bei der Produktentwicklung und schulen Ihre Mitarbeiter*innen.
Als Team des FTZ Hollabrunn unterstützen wir Lebensmittelproduzent*innen dabei, Lebensmittelsicherheit zu garantieren und Produktqualität zu sichern. Die Tätigkeiten unseres Kompetenzzentrums erstrecken sich von der klassischen chemischen und mikrobiologischen Lebensmittelanalytik, Schlachtkörperkontrolle und Hygienekontrollen im Labor bis hin zu Inhouse-Workshops, Beratung und Projektmanagement.
Wir sind seit über 16 Jahren Anlaufstelle für kleinere und mittlere Unternehmen der Lebensmittelindustrie in ganz Österreich – vom Weinviertler Landwirt über Heurigenbetriebe und Gastronomie bis hin zur internationalen Lebensmittelproduktion. Wir freuen uns über die Zusammenarbeit mit zahlreichen langjährigen Stammkund*innen aus der Region und ganz Österreich sowie immer wieder neuen Projektpartner*innen.
Unsere Leistungen
Lösungen zu allen Fragestellungen für kleine, mittlere und große Unternehmen der Lebensmittelbranche.
Schulungen, Beratungen und Projektbegleitungen für Unternehmen der Lebensmittelbranche in ganz Österreich.
Und was können wir für Sie tun?
Kontaktieren Sie uns für mehr Informationen!

